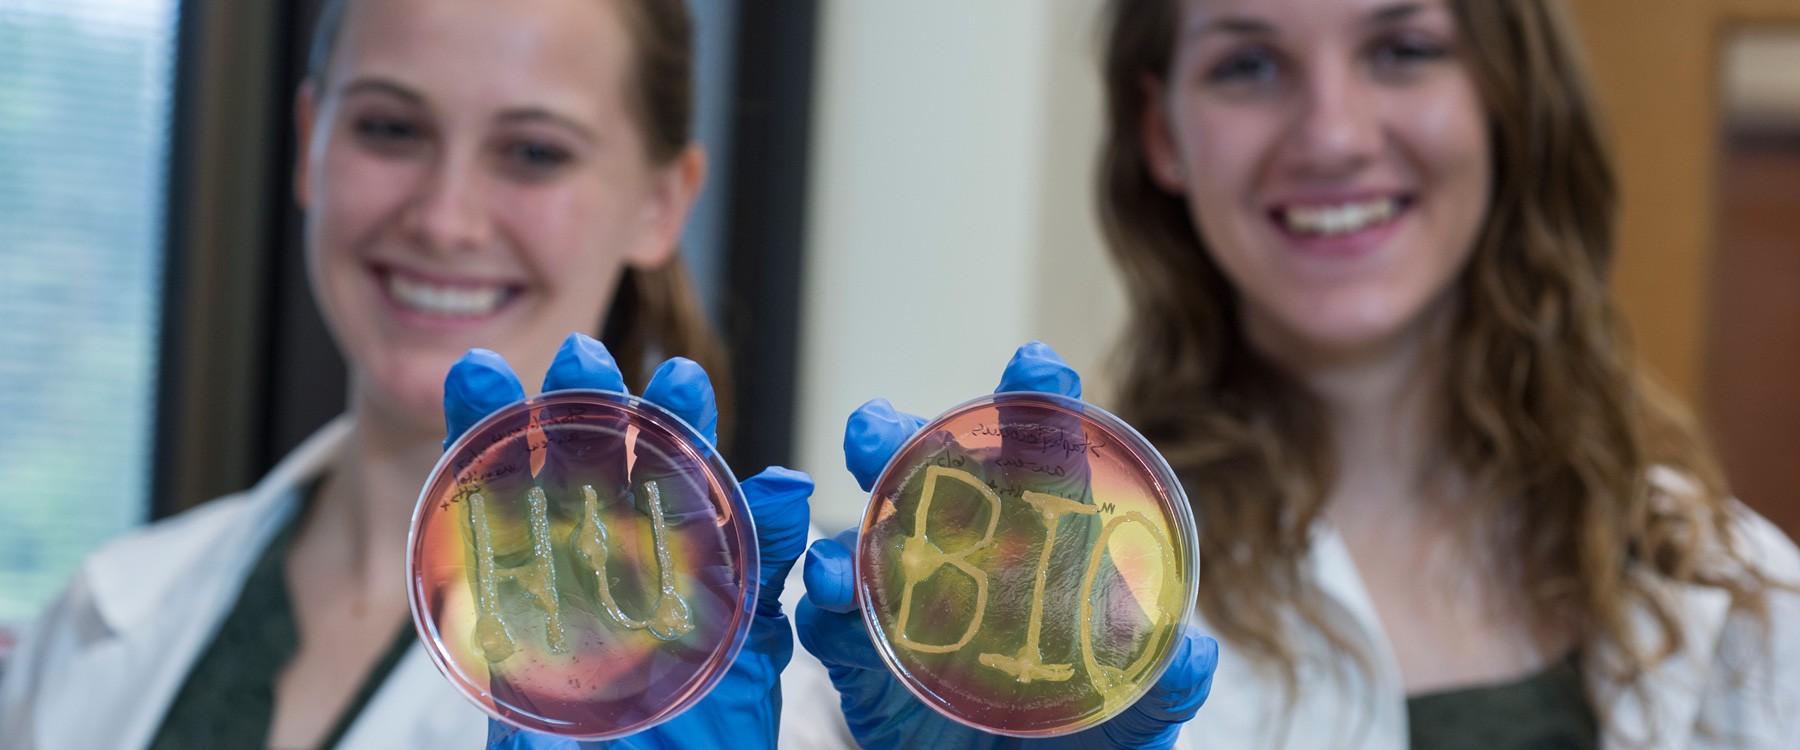

Kinesiology Majors & Minors
To see how movement and ministry meet, you need to experience what you are studying in an up-close and personal way. That’s why practical learning is built into our curriculum.
Why HU?

Cost of Attendance
Huntington University is dedicated to providing several paths for financial assistance as you invest in your education and future. Each student’s financial aid package is unique and complements our competitive tuition. Online tools are available to help you calculate your investment.
Learn More

Christ-Centered Focus
In addition to providing you with a nationally-recognized education, we aim to help you experience the cross-section between faith and education. Discover who God wants you to be alongside a close-knit, Christ-centered community. When you’re at HU, you’re home.
Learn More